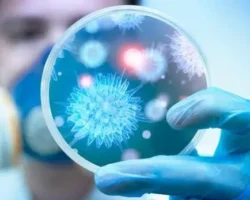
Геннадий Бочаров и ИВМ РАН делают новые шаги в понимании ВИЧ и гепатита С gennadij bocharov i ivm ran delayut novye shagi v ponimanii vich i gepatita s-t-nw-ru-0

Ученые Университета Коннектикута (США) провели важное исследование, изучив влияние природных соединений на микробиом толстого кишечника.
В эксперименте участвовали 39 мужчин и женщин 40-65 лет с повышенным риском развития колоректального рака. Все добровольцы прошли комплексное обследование, включая колоноскопию для оценки состояния кишечника.
Участники соответствовали строгим критериям: отсутствие в анамнезе онкологии, тяжелых патологий ЖКТ, гепатита, ВИЧ, а также отказ от приема антибиотиков за месяц до исследования.
Эксперты проанализировали не только медицинские показатели, но и ключевые процессы в организме, уделив особое внимание состоянию микробиома, анализам крови и маркерам воспаления.
Польза грецких орехов: уролитин А на страже здоровья
Исследователи выявили значимую роль метаболита уролитина А. Это соединение образуется при трансформации эллаготанинов (дубильных веществ) кишечными бактериями. Важно, что высокий уровень уролитина А коррелирует со снижением показателей воспалительных маркеров – предвестников онкологии.
Ключевым источником эллаготанинов, необходимых для выработки уролитина А, являются грецкие орехи. Эти растительные полифенолы не перевариваются напрямую, но ферментируются кишечной микробиотой.
В результате образуются уролитины, в том числе уролитин А, обладающие мощным противовоспалительным и противоопухолевым потенциалом.
«Уролитин А демонстрирует выраженное положительное влияние на воспаление и обладает защитными свойствами против рака. Наше исследование доказало: диета с грецкими орехами повышает уровень уролитина, одновременно снижая ключевые маркеры воспаления, даже у людей с ожирением», — подчеркивает доктор Дэниел В. Розенберг, соавтор работы.
Механизм противоракового действия
Грецкие орехи также способствуют росту уровня пептида YY – гормона, подавляющего аппетит и связанного с торможением роста опухолей. Это означает их двойную пользу: профилактику рака и сдерживание уже начавшегося злокачественного процесса.
Еще один важный эффект: орехи могут снижать уровень виментина в тканях кишечных полипов. Этот белок активно участвует в злокачественном перерождении клеток.
Как включить орехи в рацион правильно
Для поддержки здоровья рекомендуется ежедневно съедать горсть грецких орехов, идеально сочетая их с продуктами, богатыми клетчаткой. Ученые акцентируют: это эффективная мера профилактики. При уже существующем заболевании необходима профессиональная медицинская помощь.
Важна умеренность: избыток орехов не усилит защиту, но может вызвать дискомфорт в ЖКТ. Людям с аллергией на этот продукт следует исключить его из рациона.
Тревожная статистика: колоректальный рак молодеет
Традиционно колоректальный рак считался болезнью пожилых, связанной с неправильным питанием, ожирением и гиподинамией. Однако сегодня он все чаще диагностируется у молодых людей.
Эксперты отмечают четырехкратный рост заболеваемости среди лиц младше 50 лет за последние 20 лет.
«Если тенденция сохранится, к 2030 году колоректальный рак станет ведущей причиной смерти от онкологии среди молодежи», — предупреждают онкологи Калифорнийского университета в Сан-Диего.
Наибольший прирост отмечен в группе 20-29 лет. У многих молодых пациентов отсутствовали типичные факторы риска: семейный анамнез, ожирение, гипертония.
Виновник раннего рака: токсин колибактин
Разгадку нашли ученые, проанализировав 981 геном опухолей. Оказалось, что определенные штаммы кишечной палочки в толстой кишке продуцируют токсин колибактин, способный повреждать ДНК и запускать онкопроцесс.
Детские мутации и долгосрочные последствия
Воздействие колибактина в детском возрасте оставляет специфические мутации, значительно повышающие риск раннего развития рака кишечника.
«Приобретение такой мутации к 10 годам может привести к развитию колоректального рака на десятилетия раньше – в 40 лет вместо 60», — поясняет профессор Людмил Александров.
Таким образом, бактерии, вырабатывающие токсин, создают предпосылки для болезни задолго до симптомов, еще в раннем детстве. Это открытие кардинально меняет понимание причин колоректального рака.
Источник: msk1.ru